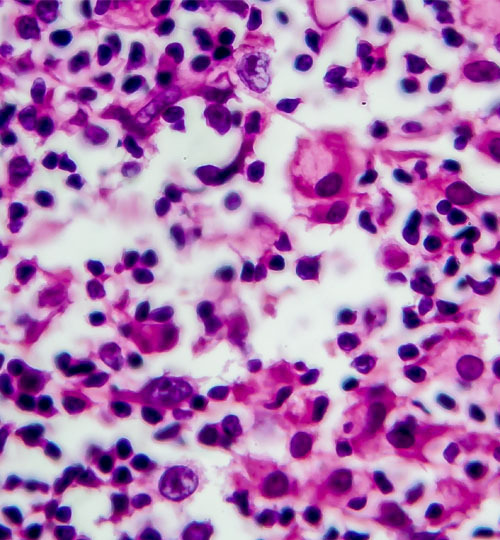
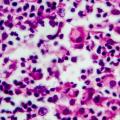

Le lymphome de Hodgkin (2 000 nouveaux cas par an) est l’un des cancers les plus curables. L’adaptation des traitements – chimio- et radiothérapie – aux facteurs pronostiques initiaux a une bonne efficacité et vise à éviter les séquelles à long terme.
Lisez notre dossier :
Rossi C, Ramla S, Robert P, et al. Lymphome hodgkinien. Surveiller la toxicité des traitements.Rev Prat Med Gen 2020;34(1045);541-5.